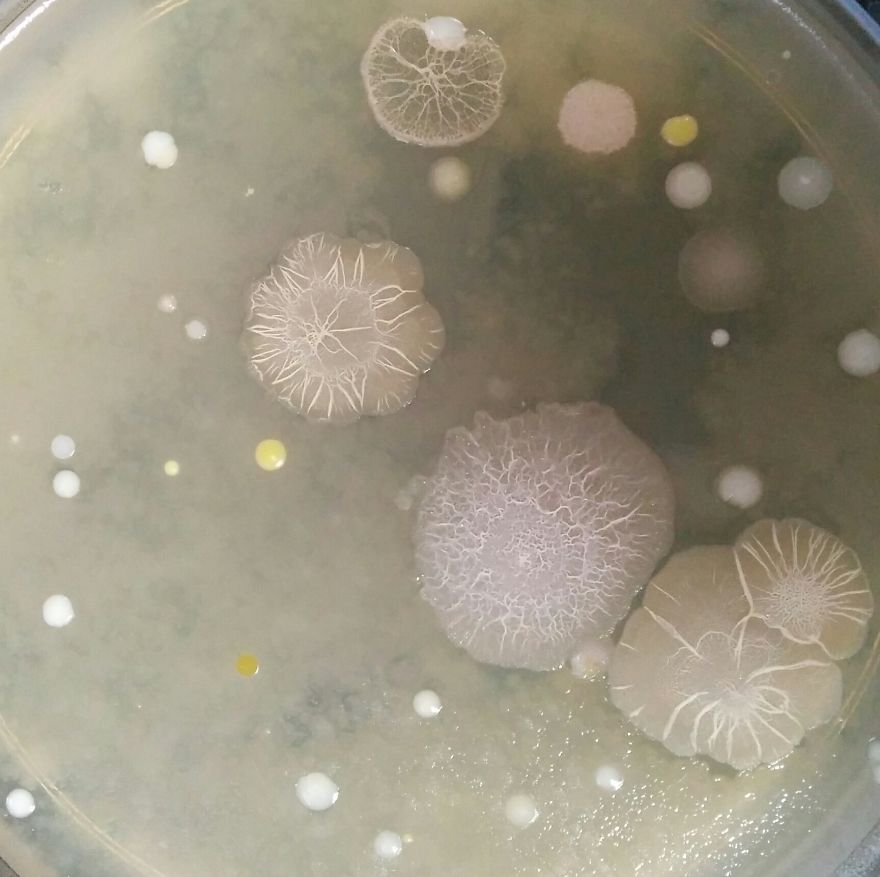
I Find Cosmos Under My Microscope And With Microbial Plate - Microsmos I Find Cosmos Under My Microscope And With Microbial Plate - Microsmos
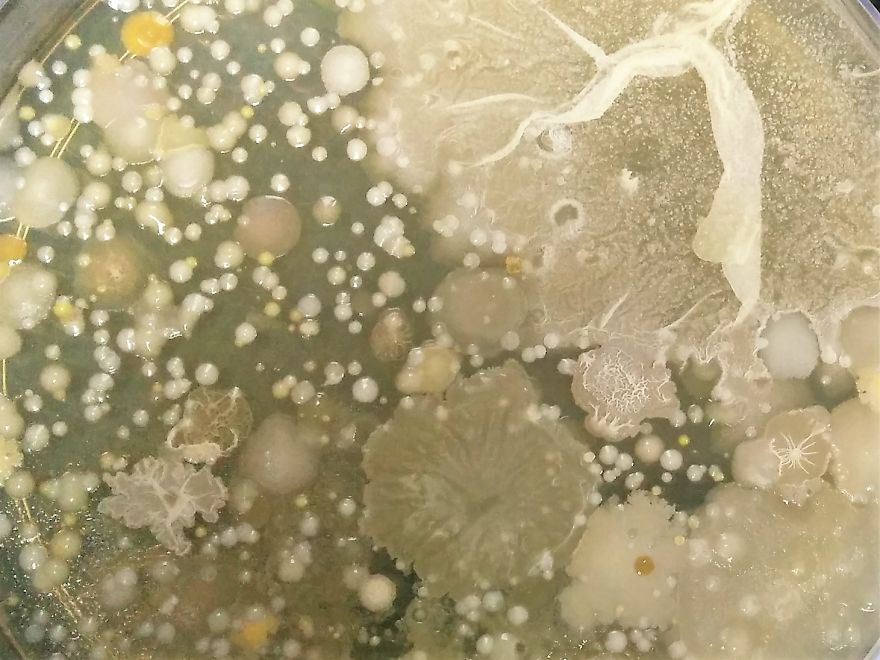
I Find Cosmos Under My Microscope And With Microbial Plate - Microsmos I Find Cosmos Under My Microscope And With Microbial Plate - Microsmos
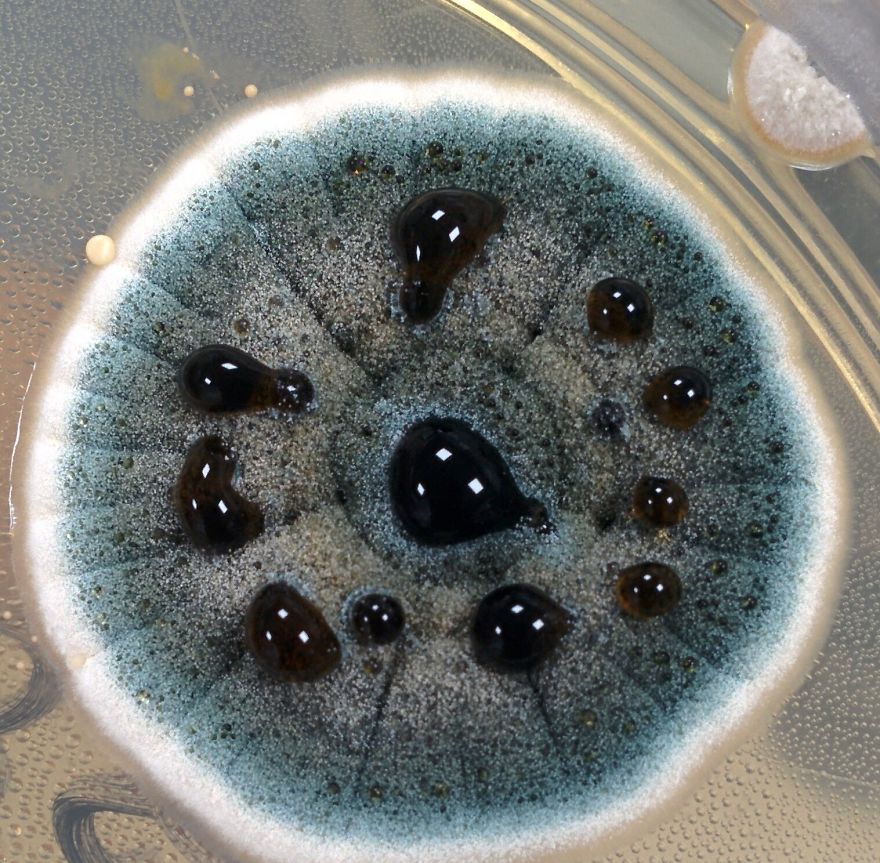
I Find Cosmos Under My Microscope And With Microbial Plate - Microsmos I Find Cosmos Under My Microscope And With Microbial Plate - Microsmos

I Find Cosmos Under My Microscope And With Microbial Plate – Microsmos
I am a microbiologist Researcher by profession, an INFJ who has an interest in many topics including life and cosmos. Well, You all must be aware of the grand cosmos which our physicist, astronomers, Space agency etc study. But you would be hardly aware of another cosmos residing within our planet, within us, the small universe of microorganism. Ok, you might just know that they cause infectious diseases but there is more to them.
They might be responsible for starting life on our planet and now they are helping to maintain it. They have their own universe which very few lucky people like us get to study them. Since 13 years into microbiology,
I have always seen fascinating structure under a microscope which has always reminded me of the grand cosmos above us. The sad part is we know more about our above cosmos than our inner microbe cosmos which hopefully in future we would explore a bit more.
Above photographs are some small section of photos which I have captured through microscopes or plates on which microbes grow. I have to try to factiously compared it with our grand cosmos. Hopefully, you like it. Do share your thoughts and also try to share your view about what does the above images look like according to you.
More info: imgur.com
Digging deep in our universe
Solar flare from a yellow dwarf stars
Galaxies
View of universe with different galaxy clusters
According to Einstein theory matter bend space time which results in Gravity. View of our universe making such spacetime curve
Black hole sucking in some galaxies
Topography of an unknown planet
An exploding Star releasing some cosmic radiation
Cluster of super wavy galaxies three of then going to collide if we will incubate it for some more time, a billion year
An expanding galaxy filled with dark energy gulping all the matter coming in its way
A crowded market in our universe. Probably there is a sale of “cheap matter” going on
Our discarded planet Pluto surface
Eclipse showing true connectivity of our universe
An unknown asteroid is on its way to burst through a Red Super giant star
Black Galaxies
Evolution of life under water on an unknown planet.
Green Cosmos with a distant super galaxy
Stars with various constellation from an unknown planet
Dark side and bright side
As we see our universe from far away it starts to look more ordered. Where is Entropy?
Black hole or a worm hole?
Grand Cosmos
layers of universe
Multiverse with multi Black hole- Are we living in a virtual reality?
A meteor probably carrying life in a new place
Floating Debris
Moon of an unknown planet
Speck of dust floating wandering in our grand cosmos
We spotted an UFO or should i say UMO- unidentified microscopic object
Very rarely but we do find UFO too. A Smiling one :)
108views
Share on Facebook

11
0